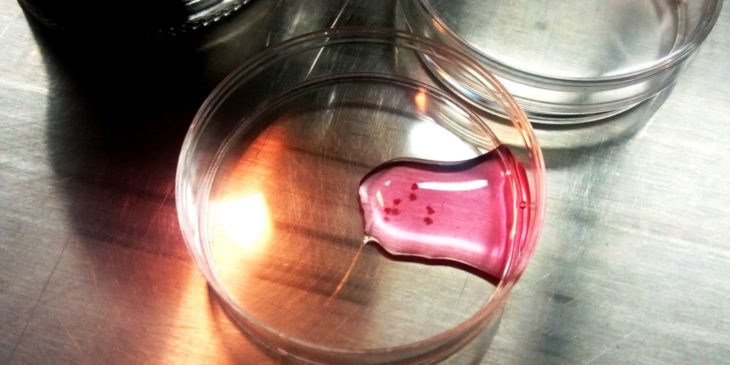

INTRODUCTION TO THE SMOOTH VS. THE SUBLIME

Patricia Piccinini, Curious Affection, Brisbane’s Gallery of Modern Art
In «Saving Beauty», Byung-Chul Han condemns and questions the “smooth” beauty – a signature of the present – in favor of the sublime beauty, the only meaningful and authentic experience of the beautiful.
“Smooth” beauty is defined as the product of today’s positive and consumeristic cultural predispositions: it does not produce any friction, nor offers any interpretations. This superficial and consumable satisfaction is heavily perpetuated in nowadays society: in the complete depilation of the skin for a perfect finish, in the production of pornographic material, in the mainstream body-subject artworks of Jeff Koons, etc. All those protocols produce an experience that abolishes any distance between the subject and the observer, creating a “haptic compulsion”, said to reflect the most pornographic and superficial aspects of contemporary reality.

Jeff Koons, Balloon Venus (Magenta), 2008-2012
On the other hand, sublime beauty relies on distance: it does not adapt, but rather just exists by itself, thereby producing a complex and painful relationship with the observer. Sublime beauty doesn’t need to please, as its existence implies a degree of concealment, a hidden meaning that triggers intellectual stimulation and “scars” the observer. This “injury” enables him to free himself from his existence to reach a moment of transcendence, of eternity. The distance from the observer removes beauty from consumption, rendering it erotic.
As a society, we are clearly experiencing a crisis of the body. How can the contemporary notion of the body be emancipatory and embody those erotic qualities that can rewrite the paradigms of beauty – making it transition from “smooth” to sublime?
________________________________________________________________________________________________
Pornography – «use another’s feelings». Pornography is direct, superficial and lacks abstraction, interpretation, or contemplation. It exhausts itself in mere pleasure.
Eroticism – derived from Eros, the Greek god of “love and sex”. Eroticism “share the power of each other’s feelings”. Eroticism promotes the human propensity for explorative curiosity, it is a primary connective and creative power”. It doesn’t appeal exclusively to our senses or carnal appetites, but also awakes and deepens our perception.
________________________________________________________________________________________________
HYPOTHESIS
Being confronted with a complex, more challenging, and sublime beauty is essential to humankind to enhance explorative curiosity and promote mental development beyond mere cognitive capacities. The injuring quality of natural beauty could arise from the evolutionary transition from mere pornography to eroticism.
The Multispecies bodies might represent an emancipatory understanding of the body that deviates from the softness pointed out by Byung Chul Han. Furthermore, a new form of eroticism with this new form of body can be produced.
WHAT IS A BODY?
A body can be defined in two ways, the first being the mechanical body; this cartesian definition describes the body in terms of the physical structure and make-up – the body as aggregated separate parts. Secondly, it can be referred to as the phenomenological body, which defines the body as a whole and not just as an object. It portrays the body as an experiential subject together with consciousness.

ebay.com, Vintage Medical Anatomy Human Organ Illustration Chart
MULTI-BODIES
The concept of a multi-body implies an interconnection or aggregation between different agencies. These blurred boundaries have been repeatedly explored in history, for example through the Chimera, a monstrous hybrid creature originating from Greek mythology. Other hybrid creatures such as the Griffon, Typhon, and Harpies further explored this multi-species concept by merging humans and animals on varying levels. Later on, the manipulation of the body was explored through the merging of different human parts creating the sapient creature, Frankenstein. The book was supposed to warn the reader over the dangers of overruling nature. Likewise, human-technology combinations have also been explored. Culturally, multi-specie bodies have all long shared a bad reputation and a negative connotation – bestiality and similar.

Chimera, Gryphon, Typhon, Harpies – Mythological Creatures
In more recent times, the concept of multi bodies and its implications has been brushed up and explored by Donna Hathaway in the essay “a Cyborg Manifesto”, where she blurs the boundaries between human and animal, and between human and machine, describing a rather positive and harmonious coexistence with and among hybrid species.
HISTORICAL TRAJECTORY

Unknown, Venus of Willendorf, c. 28 000—25 000 a. C.
Artists have been depicting eroticism since the beginning of time. One of the most ancient examples of this is The “Venus of Willendorf”, which dates back to the Paleolithic Age. Despite being extremely detailed for such a small artifact, its curious lack of any facial features elevates the Venus of Willendorf above the individual, at the same time giving it a multitude of faces. Rather than depicting a specific individual, it is the bearer of a universal message which was understood throughout Europe in its time, but will be hidden from us forever.

John White, Indian in Body Paint, 1585
Going forth in time, we have the watercolors of English artist John White, an early settler of North America. White shows body paint and tattoos, limited clothing, a “tail” in the back of the warrior, and feathers in his hair. The body here is erotic but not just because of the body paint, which was completely alien to European culture at the time, but also because of the tail. Having an animal part “merged” with the body propelled curiosity, even fear.

Joel-Peter Witkin, Ars Moriendi, 2007
Finally, looking at contemporary art, there’s the work of American artist and photographer Joel-Peter Witkin, who is famous for his disturbing photographs of the human body, nudes that are contorted or deformed but whose very freakishness moves them beyond the realm of the grotesque into the sublime. The photographs are meant to shock the viewer but they don’t aim to be repulsive; instead, they inspire curiosity.
Perhaps, the most emblematic artist to navigate the erotic, the different, the aching body is Frida Kahlo, famous for her many portraits, self-portraits, and works inspired by the nature and artifacts of Mexico. She is most famous for painting her experience of chronic pain.

Frida Kahlo, Henry Ford Hospital, 1932
Her painting Henry Ford Hospital, 1932 is directly inspired by this experience and depicts the artist bleeding on an enormous bed. Her belly is still swollen and six different elements, including a male fetus and an orthopedic cast of the pelvic zone, appear around her attached to her hand by red ribbons, as though they were umbilical cords.
“The Broken Column” in 1944 was painted shortly after the operation and sees the artist standing with her torso encased in metal belts lined with fabric to help her body from collapsing, which is emphasized by her exposed spine cracking in several places.
“The Wounded Deer” was painted towards the end of her life when her health was in decline. The antlers on Kahlo’s head are those of a stag, a male deer. Kahlo is representing herself as part male and part female, as well as elements of human and animal features. This hybrid form is often explained by the artist’s influence on pre-Columbian ideas and traditions.
There’s always at least one element in the composition which is somehow “alien”, unexpected, different, and erotic. Different parts come together to form a single body, describing the complexity of existence, pain, and loss.
STATE OF ART
Currently, the artistic framework is underpinned by transspecies, and intellectuals see the current interplay between eroticism and pornography as noteworthy.

Stelarc, Ping Body, 1996
Artists like Stelarc are fundamental for the simplification of un-framed contemporary rationalities through envisioning tech-body invasions. Although his view understands the human body as a cold-blooded vision of what post evolution requires of us, his performances incorporate emotions such as fear or anxiety with aspects of modern life.
In line with this thought, even though in a satirical manner, the “Catalog for the Post-Human” by Parsons & Charlesworth depicts a future where workers’ skills are enhanced to highlight the nature of the post-human condition. The project questions the qualities of coexistence if humans are forced to augment themselves to stay competitive.

Patricia Piccinini, Graham, 2016
Well-known artist Patricia Piccinini tackles these “embodiments” under so-called “genetic art”. Zooming in on existing biotechnological debates, her works use genetic art as sites for ethical reflections. She embraces rather than questioning technological advances, asking her audiences to think conscientiously about how they wish to use biotechnologies. By contrasting genetically modified life with human beings and crossing innocence with scientific engineering, her works evoke a narrative of scientific curiosity.
CASE STUDY
All the examples above deal with extremely spectacular body hybridizations and are artworks meant to shock and disgust. The chosen case study can be positioned on the opposite side of the spectrum, as the transition is completely invisible.
Trans*plant is a transdisciplinary project from the art performance group QUIMERA ROSA that challenges the discourse surrounding anthropocentric ecologies.

quimera rosa, TRANS*PLANT, May the Chlorophyll be with/in you
Thanks to a transversal and post-constructivist approach, the aim of the performance – an intravenous chlorophyll transfusion – is to tackle the problematic semiotical division between NATURE & HUMAN, thereby criticizing our reality’s binomial framework (man/woman, normal/abnormal,…). The subject, through the transplant, is ontologically hybrid, as it is not a plant nor a human anymore.
What implications does this collective ritual of self-experimentation have?
quimera rosa, TRANS*PLANT, May the Chlorophyll be with/in you
In this case, the dominant ecology is clearly challenged into becoming a frame of converging post-human ecologies, where the people and the world are not dualistic entities but rather embedded subjects-in-process, circulating within webs of shared relations. This paradigm shift has a great collateral impact over the power relationships through which our reality is regulated, interrogating them as both potestas (entrapment) and potentia (empowerment).
At the same time, it also poses a question of identity and tries to dismantle its concept from the traditional homogeneous, fixed, and finite entities approach in favor of more fluid possibilities.
The approach is particularly interesting, as the transition from human to plant is entirely happening underneath the surface. The hybridization of the body occurs without any clear manifestation on the outside, without spectacle. The result is eroticism in its highest form: mysterious, concealed, yet emancipatory, creative, and revolutionary.
PERSPECTIVES
In the process of hybridization, the body changes. What does the environment do to react to that change? What does it mean to design architectural space for the multi-body without reducing it to its geometrical properties? First, we must consider what designing for a traditional body means.
When designing for the body, we can historically refer to Le Corbusier’s 1948 “Le Modulor” and the conversion of measure to bodily proportions, a design that accommodates the limitations of our physical form. We can see a design on account of our traditional physicality in the “Frankfurt kitchen” too, which functionality dictated the form. When Margarete Schütte-Lihotzky designed the kitchen, the efficiency of the single user was optimized in account of the constraints of a human, and these parameters were introduced for the traditional human body form.
What could it mean, instead, to design according to a post-human and multi-body experience? How will we interact with our surroundings potentially knowing that the human form might shift and become aggregations of itself or other species? These agencies could include any number of properties and have the potential to radically shift the mindset on what “designing for humans” really means.
Multi-Bodies | Transspecies Forms of Eroticism is a project of IAAC, the Institute for Advanced Architecture of Catalonia, developed during the Master in Advanced Architecture (MAA01) 2021/22 by students: Furio Magaraggia, Jack Davis, Angelina Ovsyannikova, Emily Jane Rackstraw, Federico Caldi, and Valentina Minoletti; Faculty: Manuel Gausa and Jordi Vivaldi
REFERENCES
- Han, Byung-Chul. “Saving Beauty”, Polity Press, 2018.
- Finn, Gabrielle Maria; McLachlan, John. “A Qualitative Study of Student Responses to Body Painting”, ResearchGate Anatomical Sciences Education, January 2009.
- AL-Radaideh, Bassam. “Art and Beauty: Time and a Moment of Immortality”, IV Mediterranean Congress of Aesthetics: Art & Time, ResearchGate, June 2008.
- Ihde, Don. “Bodies In Technology”, International Feminist Journal of Politics, March, 2005.
- Volen, Bella. Art Gallery, Website,
https://bella-volen.com/about.html.
- Holmberg, Tora; Ideland, Malin. “Imagination laboratory: making sense of bio-objects in contemporary genetic art: Imagination laboratory”, The Sociological Review, Vol. 0, 2016.
- Filas, Michael. “My Dinner with Stelarc: A Review of Techno-flesh Hybridity in Art”, The Information
- Society: An International Journal, October, 2013.
- Di Dio, Cinzia; Macaluso, Emiliano; Rizzolatti, Giacomo. “The Golden Beauty: Brain Response to Classical and Renaissance Sculptures”, PLoS, Neural Bases of Aesthetics, November 2007.
- Quimera Rosa [Pink Chimera]. Website,
https://quimerarosa.net/.
- Lorde, Audre. “Uses of the Erotic: The Erotic as Power”, Crossing Press, 1984.
- Krogh, Marianne. “Connectedness. An incomplete Encyclopedia of the Anthropocene”, Strandberg Publishing, 2020.